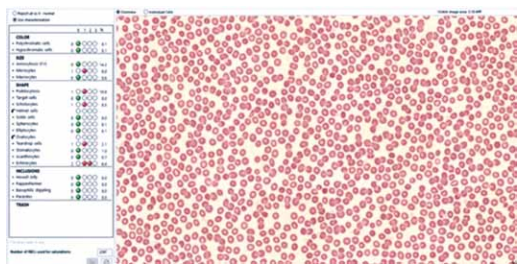
Enunciado 4377647-1

Foram encontradas 40 questões.
A cromatografia líquida de alta eficiência (HPLC) é uma
técnica analítica amplamente utilizada para separar compostos complexos em misturas intricadas.
Considerando suas características, qual das seguintes afirmações descreve o uso do HPLC na separação eficaz em amostras biológicas ou ambientais?
Considerando suas características, qual das seguintes afirmações descreve o uso do HPLC na separação eficaz em amostras biológicas ou ambientais?
Provas
Questão presente nas seguintes provas
A síndrome de Cushing é uma condição caracterizada
pela disfunção do eixo hipotálamo-hipófise-adrenal, levando a alterações metabólicas, hormonais e físicas.
Assinale a alternativa correta que descreve os valores laboratoriais associados a essa síndrome.
Assinale a alternativa correta que descreve os valores laboratoriais associados a essa síndrome.
Provas
Questão presente nas seguintes provas
Paciente masculino, 10 anos de idade, foi submetido
a curva de hormônio do crescimento (GH). O teste de
clonidina e seus valores de GH foram comparados. Um
comprimido de clonidina em pó (0,1 mg / m (2)) foi dado
por via oral e amostras de sangue para medições de GH
foram coletadas e avaliadas nos tempos 30, 0, 60, 90 e
120 min.
Qual das alternativas a seguir reflete corretamente a interpretação desses achados?

(Imagem gentilmente cedida pelo LABFMABC do Centro Universitário FMABC)
Qual das alternativas a seguir reflete corretamente a interpretação desses achados?

(Imagem gentilmente cedida pelo LABFMABC do Centro Universitário FMABC)
Provas
Questão presente nas seguintes provas
Com base na análise da figura a seguir, que mostra a
eletroforese de proteínas séricas, assinale a alternativa que estabelece a correlação clínico-patológica mais
adequada.

(Imagem gentilmente cedida pelo LAB FMABC)

(Imagem gentilmente cedida pelo LAB FMABC)
Provas
Questão presente nas seguintes provas
Em pessoas saudáveis, a síntese de coágulos é equilibrada pela fibrinólise, mediada pela enzima plasmina,
que degrada fibrinogênio e fibrina em produtos da degradação de fibrina (PDFs), evitando a oclusão dos vasos
sanguíneos.
Assinale, respectivamente, o analito oriundo do processo de fibrinólise e a metodologia padrão-ouro para avaliar processos trombóticos.
Assinale, respectivamente, o analito oriundo do processo de fibrinólise e a metodologia padrão-ouro para avaliar processos trombóticos.
Provas
Questão presente nas seguintes provas
Assinale a alternativa correta que identifica o marcador
tumoral solicitado para monitorar o tratamento e verificar
recidiva de câncer pélvico.
Provas
Questão presente nas seguintes provas
No contexto da avaliação do risco cardiovascular, a
relação entre as apoproteínas ApoA1 e ApoB, bem como
os níveis de lipoproteína(a) Lp(a), desempenha um papel
importante.
Com base no perfil lipídico e na utilização desses marcadores, qual das afirmações a seguir está correta?
Com base no perfil lipídico e na utilização desses marcadores, qual das afirmações a seguir está correta?
Provas
Questão presente nas seguintes provas
A deficiência de ferro medular é uma condição que pode impactar a hematopoiese, mesmo na presença de níveis séricos
de ferro normais.
Com base na fisiopatologia, diagnóstico e manejo dessa condição, qual das alternativas a seguir está correta?
Com base na fisiopatologia, diagnóstico e manejo dessa condição, qual das alternativas a seguir está correta?
Provas
Questão presente nas seguintes provas
Atualmente, a automação em hematologia utiliza softwares avançados que empregam redes neurais artificiais para localizar, identificar e categorizar leucócitos, eritrócitos e plaquetas no sangue periférico e medular. Essa tecnologia combina
inteligência artificial e imagem digital para automatizar a análise morfológica das células sanguíneas.

(Imagem gentilmente cedida pelo Laboratório de Análises Clínicas da FMABC)
A metodologia que auxilia na contagem qualitativa e quantitativa junto ao software é:
(Imagem gentilmente cedida pelo Laboratório de Análises Clínicas da FMABC)
A metodologia que auxilia na contagem qualitativa e quantitativa junto ao software é:
Provas
Questão presente nas seguintes provas
Em relação ao diagnóstico de sífilis, em nosso país, um
fluxograma preconizado pelo Ministério da Saúde combina ambos os tipos de testes: o não treponêmico (teste de
rastreio) e o treponêmicos para confirmação da infecção.
Contudo, há situações em que a utilização da abordagem
reversa é aplicada, ou seja, se inicia o diagnóstico com
exame laboratorial treponêmicos.
A metodologia padrão-ouro utilizada para a detecção de anticorpos totais treponêmicos é:
A metodologia padrão-ouro utilizada para a detecção de anticorpos totais treponêmicos é:
Provas
Questão presente nas seguintes provas
Cadernos
Caderno Container